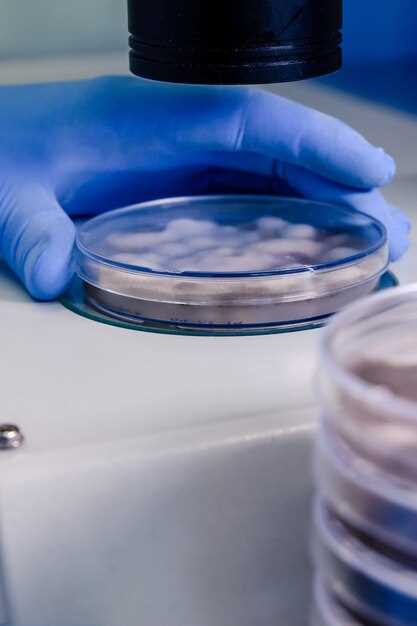
Recommended dosage of Metronidazole

Metronidazole watson labs
2026-03-17Looking for a reliable solution to manage bacterial infections? Look no further than Metronidazole by Watson Labs! Our high-quality medication is trusted by healthcare professionals worldwide for its effectiveness in treating a variety of bacterial infections.
Don't let infections hold you back. Choose Metronidazole by Watson Labs for fast and reliable relief!
Overview of Metronidazole Watson Labs
Metronidazole Watson Labs is a trusted pharmaceutical company known for producing high-quality medication, including Metronidazole. Metronidazole is a powerful antibiotic that is commonly used to treat various bacterial infections.
Key Features:
1. Effective Treatment: Metronidazole is highly effective in treating infections caused by bacteria.
2. Broad Spectrum: It is effective against a wide range of bacterial species, making it a versatile treatment option.
3. Trusted Brand: Metronidazole Watson Labs is a trusted brand in the pharmaceutical industry, known for its quality and reliability.
When you choose Metronidazole from Watson Labs, you can trust that you are getting a top-quality medication that is backed by years of research and expertise. Consult with your healthcare provider to see if Metronidazole is the right treatment option for your bacterial infection.
Benefits
Metronidazole Watson Labs offers a range of benefits for patients suffering from various infections. Some of the key advantages include:
- Efficient treatment of bacterial and parasitic infections
- Effective against anaerobic bacteria
- Can be used to treat skin, digestive, and reproductive system infections
- Reduces inflammation and symptoms of infection
- High success rate in eliminating harmful microorganisms
Key advantages of Metronidazole
Metronidazole is an effective antibiotic medication that is commonly used to treat various bacterial and protozoal infections.
1. Broad-spectrum activity
Metronidazole has a wide range of activity against both aerobic and anaerobic bacteria, making it a versatile treatment option for a variety of infections.
2. Fast action
Metronidazole is known for its rapid onset of action, often providing relief from symptoms within a few days of starting treatment.
| Advantages | Description |
|---|---|
| Effective against gastrointestinal infections | Metronidazole is particularly effective in treating gastrointestinal infections, including those caused by Clostridium difficile. |
| Topical application | In addition to oral and intravenous formulations, metronidazole is available in topical forms for the treatment of skin conditions. |
These key advantages make Metronidazole a valuable medication in the treatment of a variety of infections, offering rapid relief and broad-spectrum coverage.
Usage
Metronidazole Watson Labs is an antibiotic medication used to treat various bacterial infections, including those in the stomach, skin, joints, respiratory tract, and other areas of the body. It is also effective in treating infections caused by certain parasites.
How to take Metronidazole
- Take Metronidazole exactly as prescribed by your healthcare provider
- Follow the dosage instructions carefully to ensure effective treatment
- Swallow the tablets whole with a full glass of water
- You can take Metronidazole with or without food, but it is usually recommended to take it with food to reduce stomach upset
Recommended dosage of Metronidazole
Your doctor will prescribe the appropriate dosage of Metronidazole based on the type and severity of the infection. It is important to complete the full course of treatment even if your symptoms improve before the medication is finished. Do not stop taking Metronidazole without consulting your doctor.
Recommended dosage of Metronidazole
Metronidazole should be taken exactly as prescribed by your doctor. The dosage will depend on the condition being treated, your medical history, and other medications you may be taking.
For the treatment of bacterial infections, the usual recommended dosage of Metronidazole is 500 mg to 750 mg taken three times a day for 7 to 10 days.
Important considerations:
- Take the medication with food or milk to reduce stomach upset.
- Do not skip doses or stop taking Metronidazole early, even if you start to feel better.
- Avoid alcohol while taking Metronidazole as it can cause severe side effects.
It is essential to follow your doctor's instructions carefully and complete the full course of treatment to ensure the infection is fully cured.
Side Effects
Metronidazole Watson Labs may cause some side effects in some individuals. It is important to be aware of these potential adverse reactions:
- Nausea
- Vomiting
- Diarrhea
- Headache
- Dizziness
- Metallic taste in the mouth
- Dark urine
- Tingling or numbness in the extremities
If you experience any severe side effects or allergic reactions while taking Metronidazole, seek medical help immediately. It is essential to consult your healthcare provider before using this medication to understand the risks and benefits.
Possible adverse reactions of Metronidazole
When using Metronidazole, some patients may experience adverse reactions. It is important to consult with a healthcare professional if any of the following side effects occur:
| Common side effects: | nausea, vomiting, loss of appetite, metallic taste in the mouth |
| Less common side effects: | dizziness, headache, dry mouth, dark urine |
| Rare but serious side effects: | seizures, numbness or tingling in the hands or feet, severe skin rash |
If any severe or persistent side effects occur while taking Metronidazole, it is crucial to seek immediate medical attention.
Warnings
It is important to follow the prescribed dosage of Metronidazole Watson Labs and not exceed the recommended amount. Taking more than the recommended dose can lead to harmful side effects and adverse reactions.
Do not consume alcohol while taking Metronidazole as it can cause severe reactions and worsen side effects.
If you experience any allergic reactions such as rash, itching, swelling, or difficulty breathing, stop taking Metronidazole immediately and seek medical help.
- Avoid driving or operating heavy machinery while using Metronidazole as it may cause dizziness or drowsiness.
- Inform your healthcare provider about any other medications you are taking to avoid potential drug interactions.
- Pregnant or breastfeeding women should consult their doctor before using Metronidazole to ensure its safety for the baby.
Keep Metronidazole Watson Labs out of reach of children and store it in a cool, dry place away from direct sunlight.